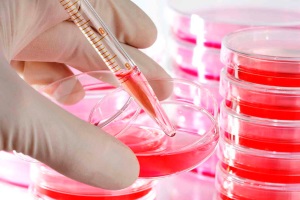
Иммуноглобулин человека антистафилококковый (human antistaphylococcus immunoglobuline) инструкция по применению

Показания и противопоказания
Лекарство назначается пациентам, у которых диагностировано заболевание, вызванное стафилококковой инфекцией. Вводят инъекции и детям, и взрослым.
Противопоказанием к введению сыворотки считаются следующие патологии:
- При анамнезе в карте пациента аллергических реакций или разного рода дерматитов. Если же аллергия была вызвана введением сыворотки или проявилась через неделю после инъекции, то ее можно назначать с одновременным приемом антигистаминных средств.
- При неправильном функционировании иммунной системы назначение иммуноглобулина оправдано только при одновременном лечении патологического состояния.
- Если в карте больного присутствует запись о сепсисе или анафилактическом шоке после введения в организм препаратов на основе человеческой крови, то назначать сыворотку категорически противопоказано.
- Если наблюдались сильные аллергические реакции на компоненты крови или плазмы, то применять средство для лечения стафилококковой инфекции тоже не рекомендуется.
Врачи отмечают, что иммуноглобулин человека антистафилококковый представляет собой важный препарат для лечения инфекций, вызванных стафилококками. Его применение оправдано в случаях тяжелых бактериальных инфекций, особенно у пациентов с ослабленным иммунитетом. Специалисты подчеркивают, что перед началом терапии необходимо провести тщательную диагностику и оценить состояние пациента. Инструкция по применению препарата содержит рекомендации по дозировке и способу введения, что крайне важно для достижения максимального терапевтического эффекта. Врачи также акцентируют внимание на возможных побочных эффектах, таких как аллергические реакции, и призывают к осторожности при использовании. В целом, при правильном применении и соблюдении всех рекомендаций, иммуноглобулин может значительно улучшить состояние пациентов и способствовать быстрому выздоровлению.

Состав и форма выпуска
Стафилококковая инфекция может поселиться в любой системе организма. Но при любой её локализации в результате интоксикации у больного будут наблюдаться высокая температура, недомогание, слабость, тошнота, рвота, сыпь. Если вовремя распознать болезнь, то можно быстро и легко восстановиться. Чтобы побороть инфекцию, делают инъекции с препаратом «Иммуноглобулин человека антистафилококковый».
В составе препарата основным действующим веществом является человеческий антистафилококковый иммуноглобулин. В одной дозе инъекционного состава содержится минимум 100 МЕ антиальфастафилолизина (специфических антистафилококковых антител). Действие активного вещества дополняют стабилизатор глицин (в концентрации 15-30 мг/мл) и хлорид натрия (содержание в растворе – 8,5-9,5 мг/мл).
Лекарственное средство представляет собой прозрачный бесцветный или немного опалесцирующий раствор. Допускается появление желтоватого оттенка. При хранении возможно оседание частиц, которые исчезают после встряхивания ампулы.
Препарат отпускают в стеклянных ампулах по 3-5 мл. Сосуды укладывают в картонные коробки по 10 штук, это количество рассчитано на основной курс лечения.
Популярные статьи на тему: антистафилококковый иммуноглобулин
Читать дальше
Инфекционные заболевания
Клинический случай тяжелого сепсиса, вызванного полимикробной ассоциацией
Грамположительные инфекции становятся все более актуальной проблемой во всем мире . По данным Европейской септической группы и Европейского консорциума по интенсивной терапии, роль грамположительных кокков в этиологии сепсиса возросла до 37% .
Читать дальше
Инфекционные заболевания
Ошибки в диагностике и лечении инфекционной патологии
В лечении классической инфекционной патологии в последние полстолетия установлены основные принципы, или протоколы, диагностики и лечения.
Читать дальше
Инфекционные заболевания
Иммунореабилитация: методы, иммунотропные препараты, принципы иммунотерапии
Иммунореабилитология – это наука, изучающая процессы восстановления функции иммунной системы до физиологической нормы под воздействием комплекса лечебно-профилактических мероприятий для достижения полного выздоровления больного.
Читать дальше
Инфекционные заболевания
Стафилококк. Вооружен, опасен, но победим
Стафилококки широко распространены в окружающей среде, многие из них постоянно живут в человеческом организме, не причиняя вреда. В то же время стафилококковая инфекция — причина многих очень серьезных заболеваний. Давайте разберемся в феномене.
Читать дальше
Травматология и ортопедия
Лечение ожоговой болезни
После оказания первой помощи больным с ожогами на месте происшествия и во время транспортировки бригада «скорой помощи» доставляет таких пациентов либо в центральную районную больницу, либо в областной ожоговый центр (если расстояние до него..
Иммуноглобулин человека антистафилококковый — это препарат, который используется для профилактики и лечения инфекций, вызванных стафилококками. Многие пациенты отмечают его эффективность в борьбе с различными инфекциями, особенно в случаях, когда традиционные антибиотики оказываются бессильны. Инструкция по применению подчеркивает, что препарат вводится внутривенно или внутримышечно, и важно строго следовать рекомендациям врача. Пользователи также отмечают, что препарат может вызывать побочные эффекты, такие как аллергические реакции, поэтому перед началом лечения необходимо провести тест на чувствительность. В целом, отзывы о препарате в основном положительные, особенно среди людей с ослабленным иммунитетом, которые отмечают улучшение состояния после курса лечения.

Побочные действия
В большинстве случаев после введения этого лекарственного средства у человека не проявляются побочные реакции. Очень редко отмечается подъем температуры тела, местные реакции в том месте, где был введен раствор.
У пациентов, у которых отмечается измененная реактивность, возможно проявление аллергических реакций. Очень редко отмечается развитие анафилактического шока. Поэтому каждый человек, получивший инъекцию Иммуноглобулина, в течение получаса должен пребывать под наблюдением специалистов. Врач при этом должен иметь доступ к средствам для противошокового лечения.
Особые указания
Концентрация белка в Иммуноглобулине антистафилококковом — 9.5-10.5%.
После введения препарата пациенты должны в течение 30 мин находиться под медицинским наблюдением. Кабинеты должны быть оснащены средствами противошоковой терапии.
Введение Иммуноглобулина антистафилококкового регистрируют в установленных учетных формах с указанием предприятия-изготовителя, номера серии, даты изготовления, срока годности, даты введения, дозы и характера реакции на введение.
Пациентам с аллергическими заболеваниями или имевшим в анамнезе клинически выраженные аллергические реакции введение препарата проводят на фоне антигистаминной терапии; при иммунопатологических системных заболеваниях (болезнях крови, соединительной ткани, нефрите и др.) — на фоне соответствующей терапии.
Препарат не является пригодным к применению, если нарушена целостность ампул или их маркировка, изменены физические свойства (помутнение, изменение цвета, появился нерастворяющийся осадок в виде хлопьев), истек срок годности и не соблюдены условия хранения.
Во избежание образования пены препарат набирают в шприц иглой с шировким просветом. После вскрытия ампулы препарат хранению не подлежит.

Люди, склонные к аллергическим реакциям, должны на фоне приёма иммуноглобулина одновременно применять антигистаминные средства. Если же симптомы аллергии обнаружились во время лечения, необходимо пройти обследование у аллерголога и только потом продолжать курс процедур.
Людям, которые работают со сложными механизмами, требующими повышенной концентрации внимания, или водят автомобили, можно продолжать заниматься такими видами деятельности на фоне терапии, поскольку антистафилококковый иммуноглобулин не влияет на скорость реакции.
Взаимодействие
Антистафилококковый иммуноглобулин используют в составе комплексной терапии, поэтому параллельно с курсом инъекций допустимо применять антибиотики.
Если пациенту предварительно ввели противовирусную вакцину, то курс противостафилококковых уколов необходимо отложить на 3 месяца, чтобы иммунная система успела выработать антитела к определённым заболеваниям.
После лечения иммуноглобулином в течение нескольких недель не стоит проводить серологические исследования, поскольку результат может быть ложноположительным.
Применение у детей
Начиная лечение детей, важно соблюдать правильность и точность дозировки. Детям до 5 лет вводят единоразово не менее 100 единиц препарата
При беременности и лактации
Действующее вещество препарата попадает к плоду через плаценту и в молоко в период лактации. Если лечение можно отложить, то лучше подождать, чтобы не нанести вред ребёнку. В том случае, когда наблюдается явная угроза для жизни и здоровья матери, то доктор принимает решение о начале медикаментозной терапии.
Условия продажи и хранения
Продать лекарство провизор может только строго по рецепту. Что касается условий хранения, то здесь есть некоторые нюансы.
Лекарственный состав рекомендуется держать в холодильнике. Это позволяет создать для него подходящие условия, после чего его можно использовать по мере необходимости. Лекарство в ампулах нельзя замораживать. Если подобное случилось, это считается нарушением правил хранения, инъецировать такой раствор запрещается.
После того, как истечёт срок годности, препарат использовать нельзя.
Показания к применению
инфекции стафилококковой этиологии у детей и взрослых.
Дозировка
Иммуноглобулин антистафилококковый вводят внутримышечно в верхний наружный квадрат ягодичной мышцы или наружную поверхность бедра.
Запрещается вводить препарат внутривенно.
До начала инъекции ампулы с препаратом выдерживают в течение 2 часов при комнатной температуре (20±2) °С. Вскрытие ампул и процедуру введения осуществляют при соблюдении правил асептики и антисептики. Во избежание образования пены препарат набирают в шприц иглой с широким просветом. Препарат во вскрытой ампуле хранению не подлежит. Не пригодны к применению препараты в ампулах с нарушенной целостностью или маркировкой, при изменении физических свойств (изменение цвета, помутнение раствора наличие неразвивающихся хлопьев), при неправильном хранении.
Доза препарата и кратность его введения зависят от показаний к применению.
При генерализованной стафилококковой инфекции минимальная разовая доза препарата составляет 5 ME антиальфастафилолизина на 1 кг массы тела взрослого человека (для детей младше 5 лет минимальная разовая доза препарата должна быть не менее 100 ME).
При более легких локальных формах — очаговых инфекциях — минимальная разовая доза препарата для взрослого человека составляет не менее 100 ME.
Курс лечения состоит из 3-5 инъекций, проводимых ежедневно или через день, в зависимости от тяжести заболевания, состояния больного и терапевтического эффекта.
Побочное действие
В редких случаях могут развиваться местные реакции в виде гиперемии кожи на участке внутримышечного введения и повешения температуры (гипертермии) до 37.5°С в течение первых суток после введения, а также диспепсические явления.
У отдельных лиц с измененной реактивностью могут развиваться аллергические реакции различного типа а в исключительных случаях — анафилактический шок, в связи с этим лица получившие препарат, должны находиться под наблюдением в течение 30 минут.
Места проведения прививок должны быть обеспечены средствами противошоковой терапии. При развитии анафилактических реакций применяют антигистаминные препараты, глюкокортикостероиды и адреномиметики.
Противопоказания
противопоказано введение иммуноглобулина лицам, имеющим в анамнезе тяжелые аллергические реакции на препараты крови человека;в случаях тяжелого сепсиса единственным противопоказанием для введения иммуноглобулина является анафилактический шок на препараты крови человека в анамнезе;лицам, страдающим аллергическими заболеваниями (бронхиальная астма атонический дерматит, рецидивирующая крапивница) или склонным к аллергическим реакциям, в день введения иммуноглобулина и в течение последующих 8 дней рекомендуется назначение антигистаминных препаратов. В период обострения аллергического процесса введение препарата осуществляется по заключению аллерголога;лицам, страдающим аутоиммунными заболеваниями (болезни крови, соединительной ткани, нефрит и т. д.), препарат следует вводить на фоне соответствующей терапии.
Применение при беременности
При беременности и в период лактации вводят только по строгим показаниям, когда предполагаемая польза для матери превышает потенциальный риск для младенца.
Синонимы нозологических групп
Оставьте свой комментарий
Опрос
Текущий индекс информационного спроса, ‰
Зарегистрированные цены ЖНВЛП
Регистрационные удостоверения Иммуноглобулин человека антистафилококковый
- Контакты издательства:
- +7 (499) 281-91-91
- E-mail: pr@rlsnet.ru
- Адрес: Россия, 123007, Москва, ул. 5-я Магистральная , д. 12.
Запрещена передача, копирование, распространение информации без разрешения ООО «РЛС-Патент». При цитировании информационных материалов, опубликованных на страницах сайта www.rlsnet.ru, ссылка на источник информации обязательна.
Еще много интересного
РЕГИСТР ЛЕКАРСТВЕННЫХ СРЕДСТВ РОССИИ РЛС , 2000-2020.
Все права защищены.
Не разрешается коммерческое использование материалов.
Информация предназначена для медицинских специалистов.
Цена Иммуноглобулина антистафилококкового, где купить
Цена препарата составляет в среднем 9600 рублей за 10 ампул. Где купить стафилококковый Иммуноглобулин, можно узнать в ближайшем медицинском учреждении.
PILULI
Иммуноглобулин антистафилококковый ампулы 100 ме, 1 доза , 5 мл, 10 шт.Биомед Красногорск, Россия
8134 руб.
Иммуноглобулин антистафилококковый ампулы 100 ме, 1 доза , 5 мл, 10 шт.Микроген НПО ФГУП, Россия
11126 руб.
еАптека
-
Иммуноглобулин антистафилококковый, Биомед Пермь, Россия, ампулы 100 МЕ, 1 доза , 5 мл, 10 шт.
10700 руб.
-
Иммуноглобулин антистафилококковый, Биомед Пермь, Россия, ампулы 100 МЕ, 1 доза , 5 мл, 10 шт.
7990 руб.
-
Иммуноглобулин антистафилококковый, Биомед Пермь, Россия, ампулы 100 МЕ, 1 доза , 5 мл, 10 шт.
11113.61 руб.
Внимание, только СЕГОДНЯ!
Source: medicsguru.ru
Показания и противопоказания к применению
Единственное показание к применению описываемого препарата – стафилококковая инфекция
Используя лекарство как средство борьбы с ней, стоит обратить внимание на разновидности заболеваний данной этиологии и их признаки
- Нарушения в работе желудочно-кишечного тракта. В этом случае у больного поднимается температура, наблюдаются тошнота, рвота, диарея.
- Высыпания на коже. На поверхности дермы наблюдается обилие карбункулов, фурункулов. Кожные проявления сопровождаются слабостью, недомоганием и иногда подъёмом температуры.
- Пневмония. Часто протекает бессимптомно, поэтому при несвоевременной диагностике может привести к обструкции и летальному исходу.
- Воспаления ЛОР-органов. В ушах, в носу, на слизистых оболочках носоглотки, горла наблюдаются гнойники, которые вызывают болевые ощущения, вялотекущее воспаление, слабость, подъём температуры.
- Синдром «ошпаренной кожи». Обычно встречается у новорождённых и детей младшего возраста. Заболевание характеризуется обилием высыпаний, напоминающих ожог.
При наличии этих симптомов, которые спровоцированы стафилококком, назначают инъекции с описываемым препаратом.
В некоторых случаях, когда наблюдается индивидуальная непереносимость лекарства, вероятны последствия в виде анафилактического шока, средство использовать нельзя. Если развиваются аллергические реакции на фоне приёма лекарства, то дополнительно назначают антигистаминные средства. Собственно, гиперчувствительность к компонентам лекарственного состава – единственное противопоказание к его применению.
Способ применения и дозировка
Антистафилококковый иммуноглобулин вводят внутримышечно в ягодицу или наружную часть бедра.
- Взрослому человеку рассчитывают дозировку, исходя из массы тела – 5 единиц лекарства на 1 кг веса.
- Детям вводят не менее 100 единиц за один раз.
- Курс лечения составляет от 3 до 5 дней. Можно делать инъекции каждый день или через день – порядок введения препарата и дозировку рассчитывает врач.
Побочные действия и передозировка
После введения иммуноглобулина у больных иногда поднимается температура, а в месте выполнения укола возникает покраснение.
На коже могут обнаружиться высыпания аллергической природы. При особой чувствительности к компонентам препарата у пациентов развивается анафилактический шок. Чтобы избежать негативных последствий, больной после процедуры должен не менее получаса находиться под наблюдением врачей, у которого есть антигистаминные и противошоковые средства.
Во время исследований и в клинической практике случаи передозировки антистафилококковым иммуноглобулином описаны не были. Но нужно контролировать симптомы побочных эффектов и вовремя обращаться в больницу, чтобы предотвратить причинение вреда организму.
Вопрос-ответ
Для чего назначают иммуноглобулин человеческий?
Неврологи назначают простой иммуноглобулин человека пациентам, страдающим рассеянным склерозом, хронической воспалительной демилиенизацией при полиневропатии, миастении. Педиатры используют препарат для профилактики и лечения инфекций у новорожденных, недоношенных и детей, родившихся с низкой массой тела.
Для чего антистафилококковый иммуноглобулин?
Показания к применению Лечение заболеваний стафилококковой этиологии у детей и взрослых.
Для чего выписывают иммуноглобулин?
Внутривенные иммуноглобулины применяют при иммунодефицитных состояниях, например, при Х-связанной агаммаглобулинемии (первичное иммунодефицитное состояние), при вторичных иммунодефицитах, при воспалениях и аутоиммунных заболеваниях, при острых инфекциях.
Кому нельзя колоть иммуноглобулин?
При тяжелой аллергии на предыдущий укол препарата (это встречается крайне редко)при наличии антирезусных антител в крови женщины (независимо от срока беременности)
Советы
СОВЕТ №1
Перед использованием иммуноглобулина человека антистафилококкового обязательно проконсультируйтесь с врачом. Он поможет определить необходимость применения препарата и подберет подходящую дозировку в зависимости от вашего состояния здоровья.
СОВЕТ №2
Обратите внимание на возможные побочные эффекты и противопоказания, указанные в инструкции. Это поможет избежать нежелательных реакций и обеспечит безопасность во время лечения.
СОВЕТ №3
Следите за сроками хранения и условиями хранения препарата. Иммуноглобулин должен храниться в холодильнике и не должен подвергаться замораживанию, чтобы сохранить свою эффективность.
СОВЕТ №4
Записывайте все изменения в своем состоянии во время лечения и сообщайте об этом врачу. Это поможет ему оценить эффективность терапии и при необходимости скорректировать лечение.